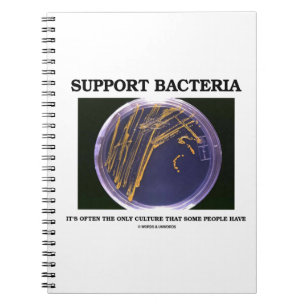
Carnet Support Bacteria

Support Carnets
115 résultats
Carnet Support d'arbre
Prix18,85 $CA
Carnet Élégant rose clair simple minimaliste moderne
Prix20,05 $CA
Carnet Simple minimaliste blanc classique élégant
Prix20,05 $CA
Carnet Support your Lineman
Prix20,55 $CA
Carnet 1 Corinthiens 13:7 L'amour supporte tout
Prix18,85 $CA
Carnet Le support fort, soit vous-même citation de
Prix17,85 $CA
Carnet I work to support my reading addiction
Prix18,85 $CA
Carnet Conception d'une propriété avec plans d'intérieur
Prix18,85 $CA
Produit sous licence officielle
Carnet Éduquer le support de l'avocat...MS
Prix17,85 $CA
Carnet Funny Hysterectomy Support Uterus Remoding
Prix18,25 $CA
Carnet Support Bacteria
Prix18,85 $CA
Carnet Uterus Removal Surgery support Hysterectomy
Prix18,25 $CA
Carnet Hystérectomie Support Uterus Suppression
Prix18,25 $CA
Carnet VOTE Books Uterus LGBT Support
Prix18,65 $CA
Carnet Belle Diversité Citation Pro Immigration
Prix18,85 $CA
Carnet Guide Support Change, Social Worker
Prix21,10 $CA
Carnet Tableau de fleurs sur support mixte
Prix40,65 $CA
Carnet Support d'exposition de berger allemand
Prix20,05 $CA
Je Me Trouve Avec Des Gens Trans Carnet Spiral Per
Prix18,25 $CA
Rainbow Kaleidoscope Journal - CTFOD spectre
Prix27,60 $CA
F*ck Depression Journal - Édition Script CTFOD
Prix27,60 $CA
Carnet Père Noël
Prix18,85 $CA
"Il n’y a rien de mal à vous" Carnet Spiral
Prix27,60 $CA
Carnet Citation d'amitié par Vincent van Gogh
Prix17,85 $CA
Carnet Votre équipe de football en rouge
Prix18,85 $CA
Carnet Agile tenez les notes
Prix17,85 $CA
Juin est le mois de sensibilisation au SSPT Carnet
Prix18,05 $CA
Carnet Donation Collection conseil pot ajouter votre q r
Prix40,65 $CA
Carnet Fungus polypores sur souche d'arbre
Prix27,60 $CA
Carnet Impression fractale descendante du corbeau
Prix20,55 $CA
Free Palestine Carnet - Solidarity Journal
Prix17,85 $CA
La Promesse Zazzle
Garantie Coup de Coeur
Vous ne l'aimez pas ? Nous le reprenons ! 30 jours pour choisir, notre "Garantie 100% coup de cœur".
Livraison Internationale Simplifiée
Expédition sans soucis, sans frais cachés. Nous couvrons les frais de douane.
Achats Sécurisés Garantis
Paiement 100% sécurisé grâce au cryptage SSL.
Avis sur la recherche
Si vous avez besoin d'assistance ou si vous avez une question, consultez notre Aide
Articles vus récemment